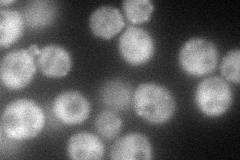
YLR337C
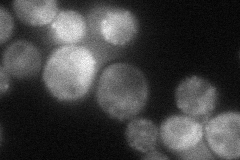
YLR337C
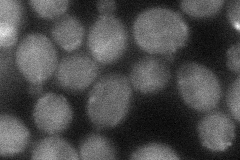
YLR337C

View description
Proline-rich actin-associated protein involved in cytoskeletal organization and cytokinesis; related to mammalian Wiskott-Aldrich syndrome protein (WASP)-interacting protein (WIP)
Localization:
Intensity:
Fold change:
Significance:
-
C’ GFP library in SD

punctate37.94 -
N' NOP1pr-GFP in SD
cytosol,punctate84.9509 -
N' TEF2pr-mCherry in SD
punctate,bud neck35.2448 -
N' NATIVEpr-GFP in SD

punctate,bud neck33.7162 -
N' TEF2pr-VC and Cyto-VN in SD
cytosol42.6416 -
C’ GFP library in SD+DTT

punctateN/AN/ANo -
C’ GFP library in SD+H2O2

technical problem0N/ANo -
C’ GFP library in Starvation Media

punctateN/AN/AYes -
C’ GFP library on the background of Pup2-DaMP

punctate -
C’ GFP library on the background of CCT mutant

punctateN/AN/ANo
